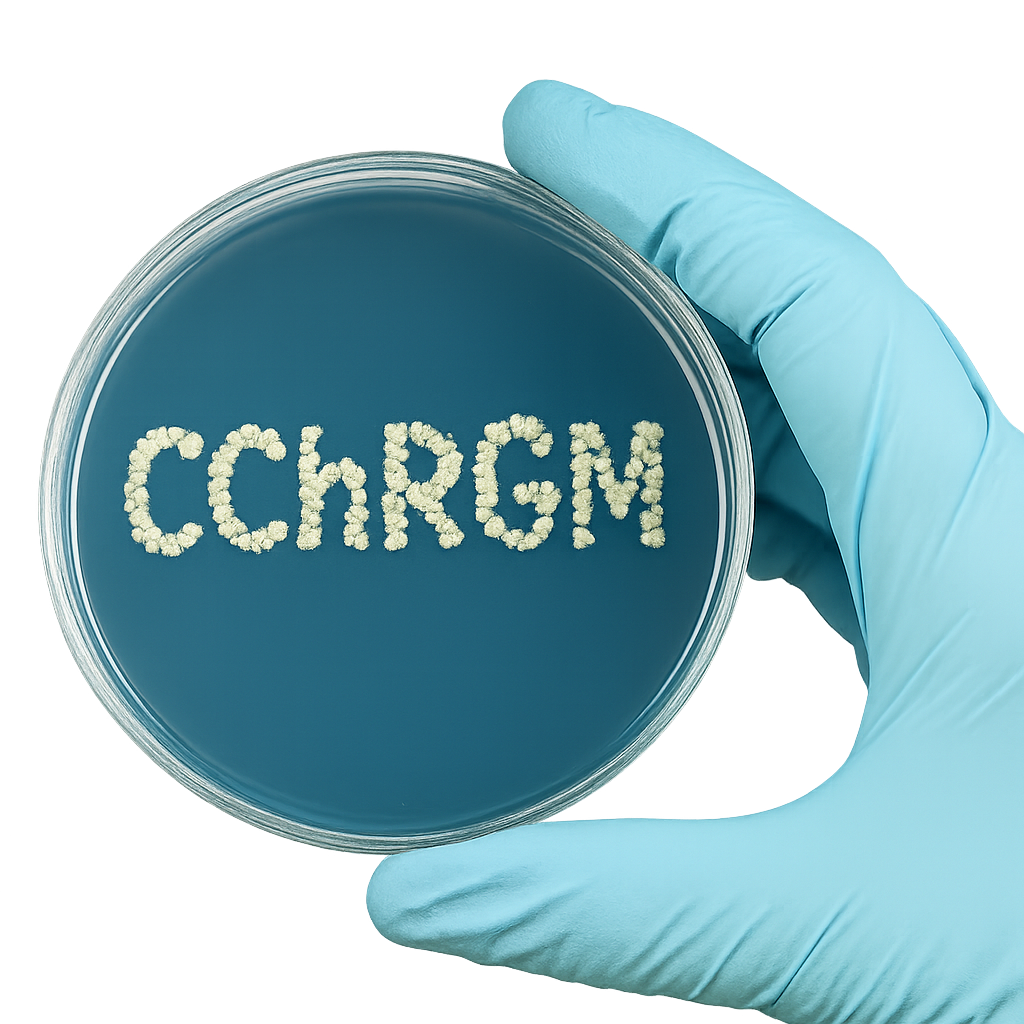
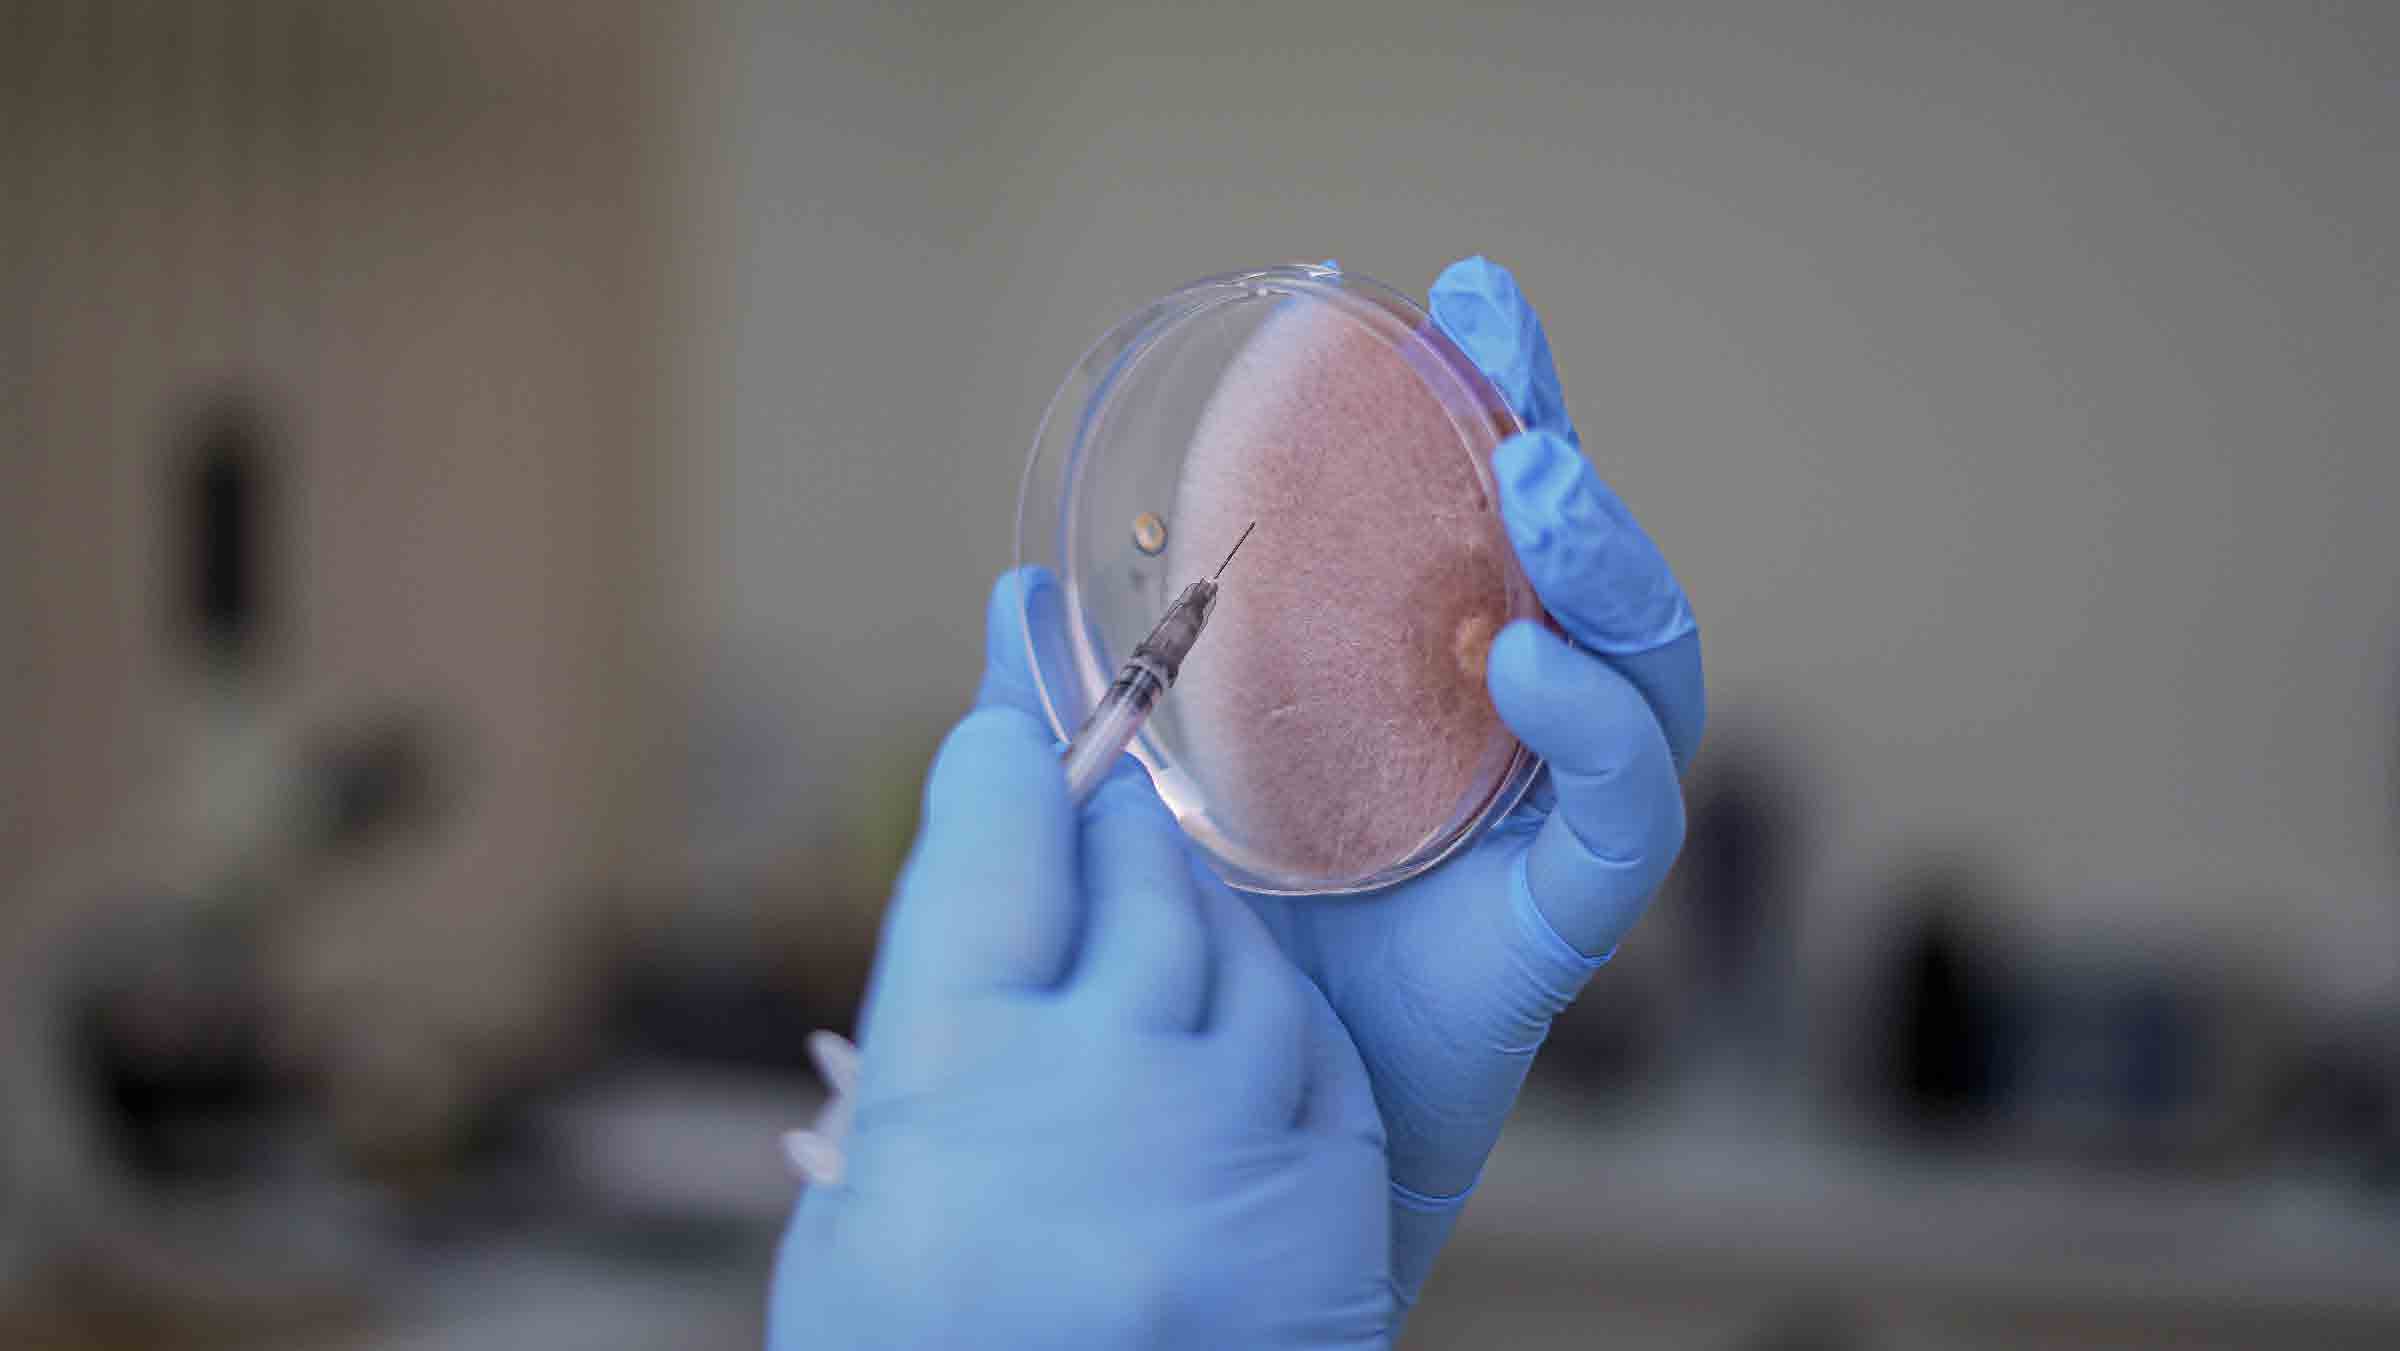
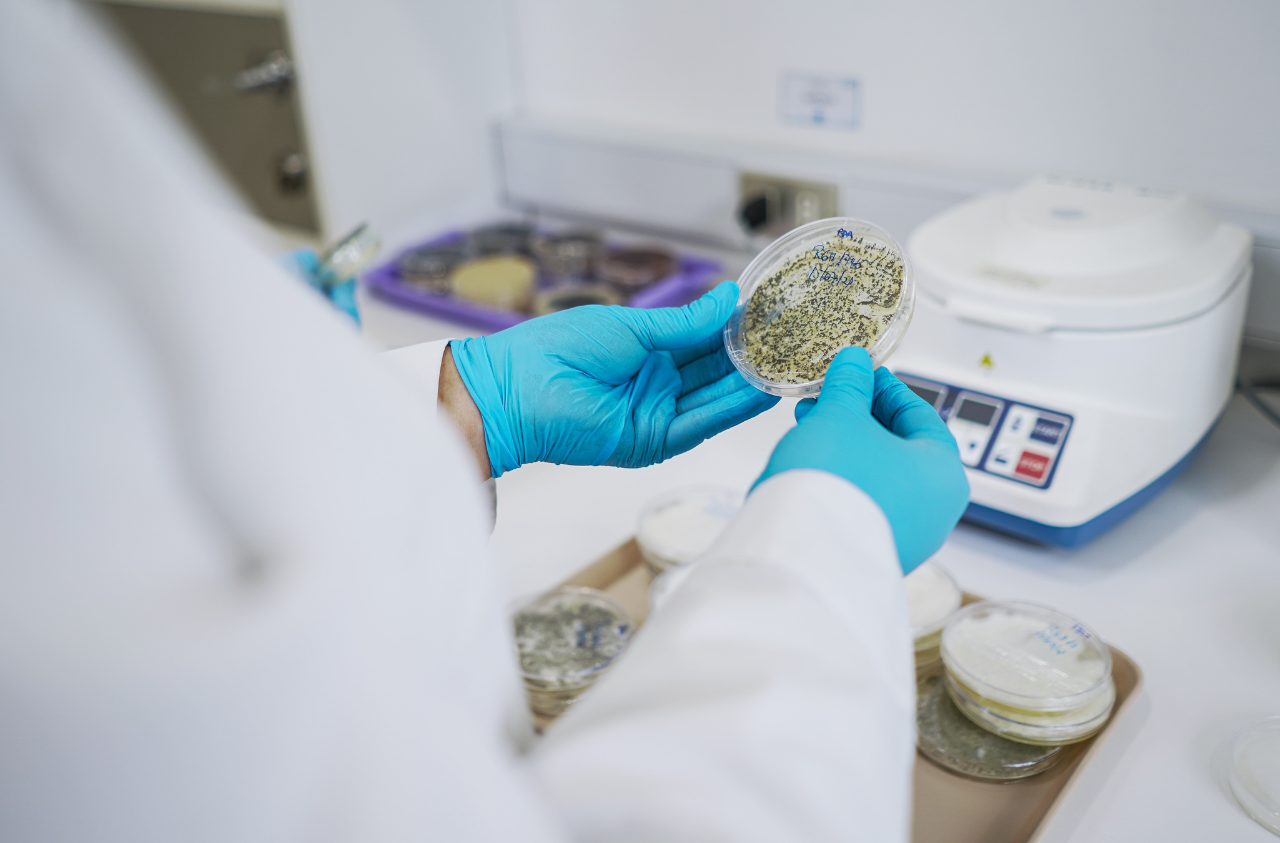

Colección Chilena de Recursos Genéticos Microbianos
Preservando y valorando los Recursos Microbianos de Chile

CChRGM
Conservando la diversidad microbiana de Chile
Impulsamos la investigación y la innovación para poner en valor los microorganismos como aliados clave en el desarrollo de una agricultura sostenible y resiliente.
Servicios Especializados
Apoyo técnico y científico para investigadores, empresas y emprendedores
Depósito seguro de cultivos microbianos a corto y largo plazo.
Diagnóstico fitopatológico para la detección e identificación de enfermedades en plantas.
Identificación molecular de microorganismos.
Evaluación de calidad de bioinsumos, incluyendo pureza y viabilidad de cepas
Cursos y capacitaciones personalizadas.

Modalidades de Conservación
Servicios de conservación de microorganismos
La CChRGM ofrece tres modalidades de conservación adaptadas a las necesidades de la comunidad científica, académica e industrial. Cada opción garantiza trazabilidad, pureza y viabilidad para el resguardo de cepas microbianas.
Público
Privado
Patentamiento
